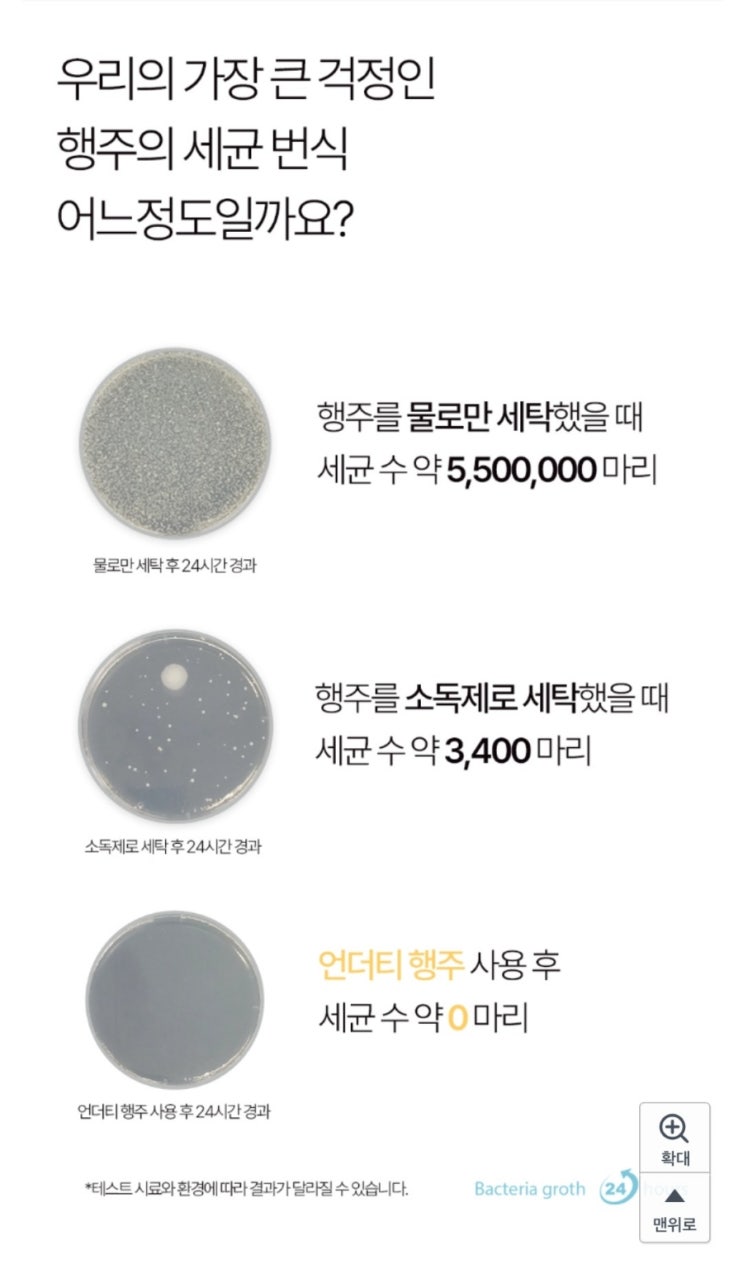

[금천/가산] 가디역점심 한우마당_육회비빔밥
2024.08.23

오랜만에 팀끼리 먹게된 점심 !! 사실 가산이 식당이 거기서거기라 좀 고민하다가 일단 뭔가 많은 한라원앤...
출처
https://blog.naver.com/m_oal0112/223531997583
이슈모어 핫이슈
-
 서태지 컴백 기다리는 팬들 술렁, 120편 복원 프로젝트 끝낸 뒤 남긴 새로운 예고
서태지 컴백을 기다리는 팬들의 관심이 다시 커지고 있다. 가수 서태지가 약 2년 동안 이어온 4K 업스케일링…
서태지 컴백 기다리는 팬들 술렁, 120편 복원 프로젝트 끝낸 뒤 남긴 새로운 예고
서태지 컴백을 기다리는 팬들의 관심이 다시 커지고 있다. 가수 서태지가 약 2년 동안 이어온 4K 업스케일링…
-
 참교육 임한림 진기주 파격 변신, 삼성 출신 배우가 넷플릭스에서 보여준 새로운 얼굴
참교육 임한림으로 변신한 배우 진기주가 넷플릭스 시리즈 공개 이후 새로운 얼굴을 보여주며 주목받고 있다. 그…
참교육 임한림 진기주 파격 변신, 삼성 출신 배우가 넷플릭스에서 보여준 새로운 얼굴
참교육 임한림으로 변신한 배우 진기주가 넷플릭스 시리즈 공개 이후 새로운 얼굴을 보여주며 주목받고 있다. 그…
-
 옥택연 일등머슴 용길이 결혼 후 첫 사극 복귀작으로 선택한 이유
옥택연 일등머슴 용길이 출연 소식이 전해지며 가수 겸 배우 옥택연의 새로운 행보에 관심이 집중되고 있다. 오…
옥택연 일등머슴 용길이 결혼 후 첫 사극 복귀작으로 선택한 이유
옥택연 일등머슴 용길이 출연 소식이 전해지며 가수 겸 배우 옥택연의 새로운 행보에 관심이 집중되고 있다. 오…
관련 포스팅
Copyright blog.dowoo.me All right reserved.